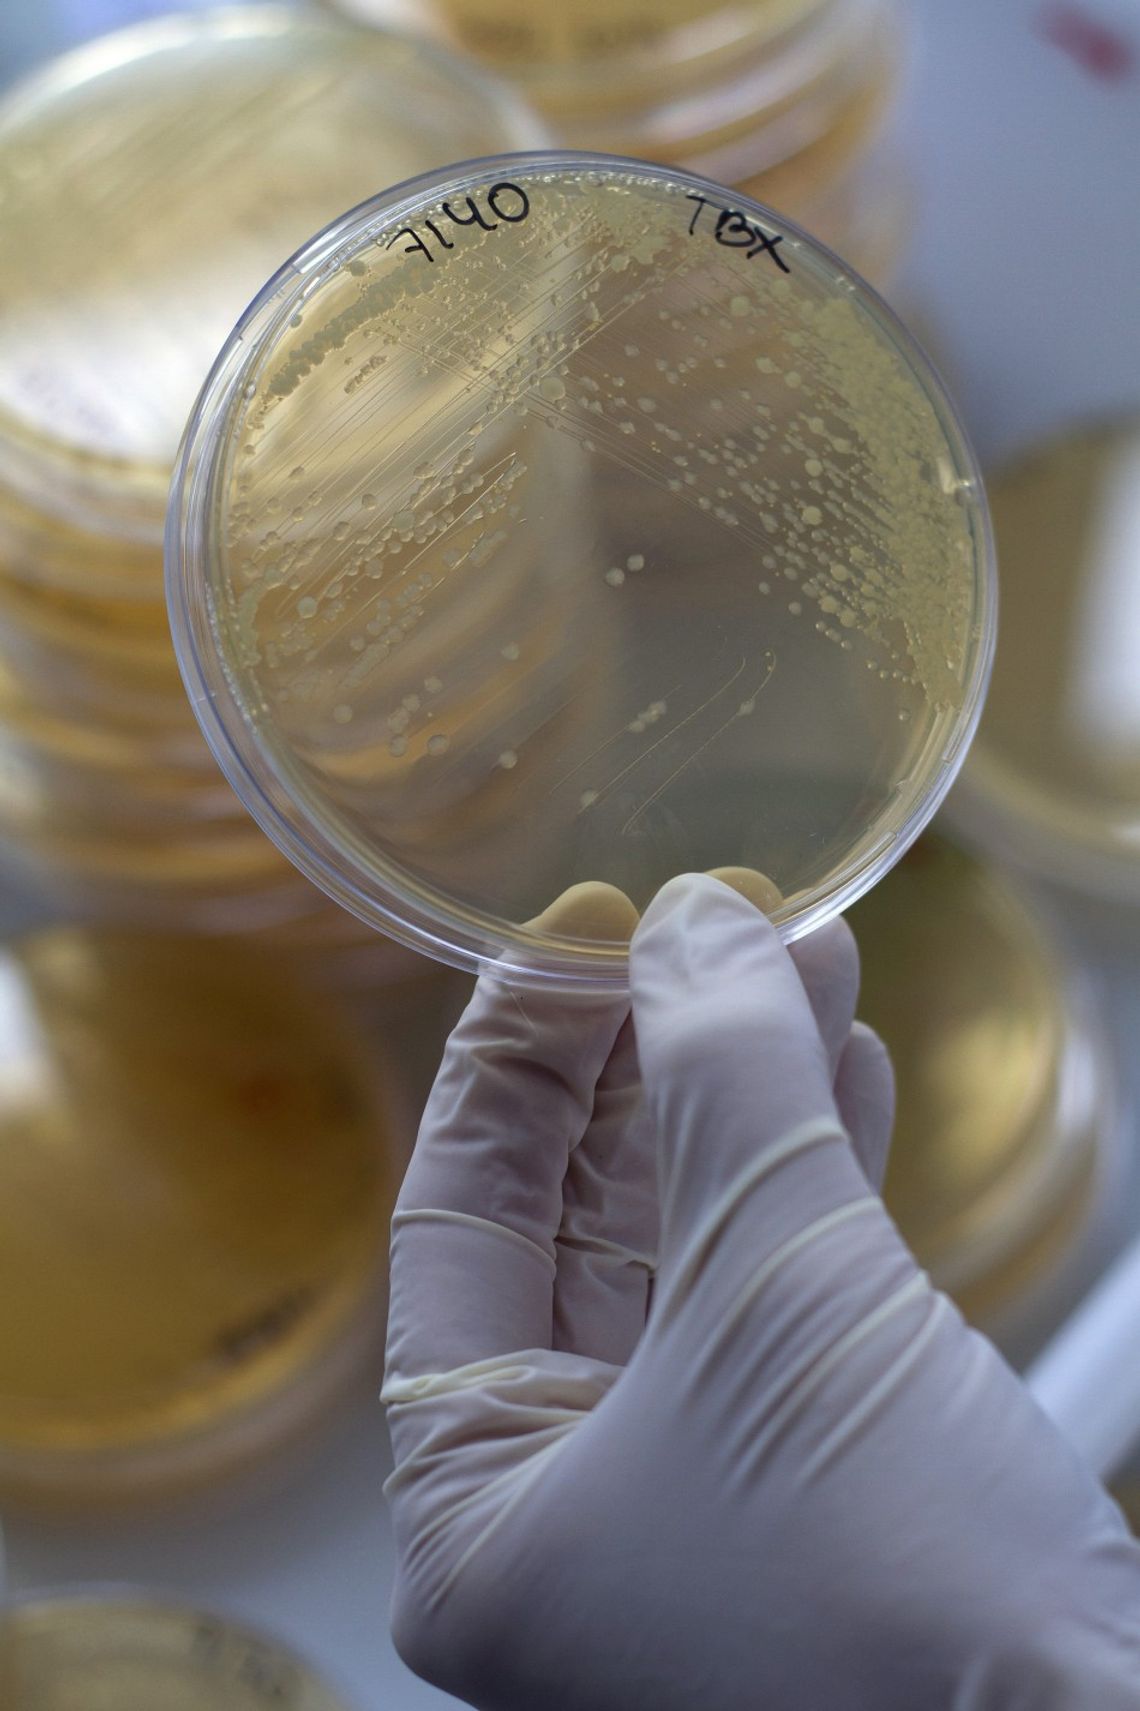
Sanepid wykrył w Polpharmie bakterie E coli!

Niepokojącego odkrycia w Polpharmie dokonał dzisiaj sanepid. W wodzie znaleziono groźną bakterię E coli (Pałeczka Okrężnicy). W związku z tym wszystkich pracowników zwolniono wcześniej do domu.
- Potwierdzam, że w czasie badania próbki wody głębinowej na terenie jednego z budynków Zakładów Farmaceutycznych Polpharma SA stwierdzono przekroczenie dopuszczalnego stężenia bakterii z grupy Eschericha coli. Niezwłocznie rozpoczęto proces dezynfekcji sieci wody głębinowej, która będzie trwała przez cały weekend. Woda głębinowa nie jest używana w Polpharmie w procesach technologicznych związanych z produkcją leków, a jedynie do celów sanitarnych. Dla zapewnienia bezpieczeństwa pracowników na terenie całego zakładu odcięto dopływ wody, zabezpieczając niezbędne potrzeby sanitarne wodą z dystrybutorów i beczkowozów. W czasie dezynfekcji działalność operacyjna zakładu została ograniczona do minimum. W ramach działań prewencyjnych skrócono czas pracy. Przywrócenie normalnej działalności operacyjnej planowane jest w poniedziałek – tłumaczy Magdalena Rzeszotalska, rzeczniczka prasowa Polpharmy.
Pałeczki E coli to groźne bakterie, choć najczęściej powodują jedynie zatrucie pokarmowe mogą również być przyczyną zakażenia dróg moczowych, zapalenia opon mózgowo – rdzeniowych, a w skrajnych wypadkach nawet sepsy.

Napisz komentarz
Komentarze